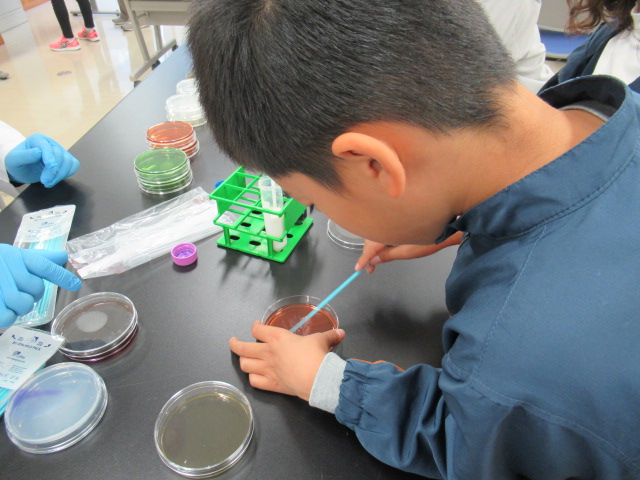
微生物検査体験

環境保健研究センターでは、令和7年11月30日(日曜日)に施設の一般公開を開催しました。
今年度の一般公開は、普段は一般の方が入ることができない、「研究ゾーン」を開放し、研究員がご説明するラボツアーと、各種体験・展示を行い、多くの方に来場していただきました。当日の様子をご紹介します。
ラボツアー
ラボツアーは、「遺伝子検査・ゲノム解析」、「マイクロプラスチック」、「大村湾の水質分析・ツシマヤマネコ」、「食品検査」の4コースを開催、どのラボツアーも盛況となりました。
体験・クイズ・展示
ツシマヤマネコ事業の展示、ちりめんモンスター、微生物検査体験、感染症クイズ、生物多様性見える化展、気候変動・放射能の展示を行いました。
最後に
当日は天候にも恵まれ、たくさんの方々にご来場いただき大盛況となりました。
参加していただいた皆様が、保健衛生や環境問題等に興味・関心を深めていただく一助となれば幸いです。
次回、さらにパワーアップした企画・展示を検討しますので、ぜひまたお越しください。
ありがとうございました。
このページの掲載元
- 環境保健研究センター
- 郵便番号 856-0026
長崎県大村市池田2丁目1306番地11 - 電話番号 0957-48-7560
- ファックス番号 0957-48-7570